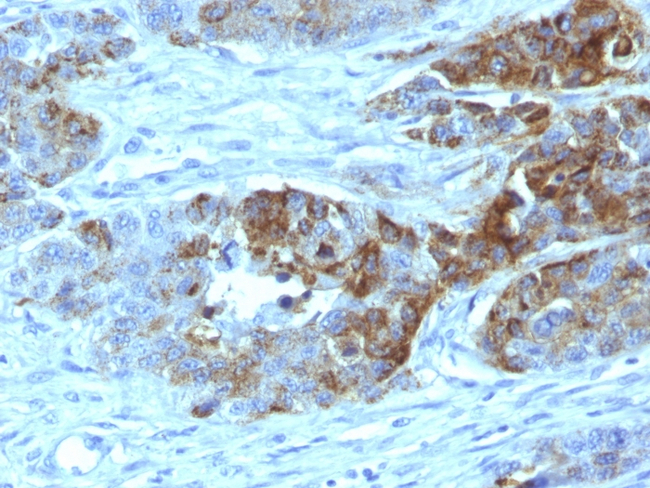
Blood Group Antigen H Type 2 (CD173) Antibody in Immunohistochemistry (Paraffin) (IHC (P))

Search
NeoBiotechnologies
Blood Group Antigen H Type 2 (CD173) Monoclonal Antibody (19-OLE)
{{$productOrderCtrl.translations['antibody.pdp.commerceCard.promotion.promotions']}}
{{$productOrderCtrl.translations['antibody.pdp.commerceCard.promotion.viewpromo']}}
{{$productOrderCtrl.translations['antibody.pdp.commerceCard.promotion.promocode']}}: {{promo.promoCode}} {{promo.promoTitle}} {{promo.promoDescription}}. {{$productOrderCtrl.translations['antibody.pdp.commerceCard.promotion.learnmore']}}
产品信息
28-MSM1-P1BX
种属反应
宿主/亚型
分类
类型
克隆号
抗原
偶联物
形式
浓度
规格
纯化类型
保存液
内含物
保存条件
运输条件
产品详细信息
Product cellular localization: Apical cell membrane, Cell membrane, Endosome, Membrane raft, Secreted, Zymogen granule membrane.
Positive control: Pancreas: Acinar cells should show a strong immunostaining with apical predominance. Duodenum: Glandular cells of Brunner glands should show a weak to moderate GP2 positivity.
Tissue specificity: Expressed in pancreas (at protein level) (PubMed:8666297, PubMed:10760606). Specifically expressed by M (microfold) cells which are atypical epithelial cells of the intestine (at protein level) (PubMed:19907495).
靶标信息
The H antigen is a precursor to the ABO blood groupantigens, present in people of all common blood types. The Bombay phenotype (hh) does not express antigen H on red blood cells, and therefore this type will also lack A or B antigens, similar to the O blood group. However, unlike O group, the H antigen is absent, hence the individuals produce isoantibodies to antigen H as well as to both A and B antigens. If they receive blood from someone with O blood group, the anti-H antibodies will bind to the H antigen on the red blood cells of the donor blood and destroy the RBCs bycomplement-mediated lysis. Therefore, people with Bombay phenotype can receive blood only from otherhhdonors, although they can donate as though they were type O. Some individuals with the blood group A1 may also be able to produce anti-H antibodies due to the complete conversion of all the H antigen to A1 antigen. Production of the H antigen, or its deficiency in the Bombay phenotype, is controlled at the H locus on chromosome 19. The H locus contains threeexonsthat span more than 5kbof genomic DNA, and encodes thefucosyltransferasethat produces the H antigen on RBCs. The H antigen is a carbohydrate sequence withcarbohydrateslinked mainly to protein (with a minor fraction attached toceramidemoiety).
仅用于科研。不用于诊断过程。未经明确授权不得转售。
篇参考文献 (0)
生物信息学
蛋白别名: A transferase; ABH; ABO blood group (transferase A, alpha 1-3-N-acetylgalactosaminyltransferase; transferase B, alpha 1-3-galactosyltransferase); alpha 1-3-N-acetylgalactosaminyltransferase; Any polymorphism or mutation that changes the activity or specificity of the encoded enzyme may therefore alter the ABO phenotype.; B transferase; B(A) alpha-1,3-galactosyltransferase; Bel; BG-H; BG-H1; Fucosylglycoprotein 3-alpha-galactosyltransferase; Fucosylglycoprotein alpha-N-acetylgalactosaminyltransferase; Glycoprotein-fucosylgalactoside alpha-galactosyltransferase; Glycoprotein-fucosylgalactoside alpha-N-acetylgalactosaminyltransferase; Histo-blood group A transferase; histo-blood group A transferase (UDP-GalNAc); histo-blood group A2 transferase; Histo-blood group ABO system transferase; Histo-blood group B transferase; NAGAT; transferase A; A glycosyltransferase; transferase B; Unknown; unnamed protein product
基因别名: A3GALNT; A3GALT1; ABO; GTB; NAGAT
UniProt ID: (Human) P16442
Entrez Gene ID: (Human) 28